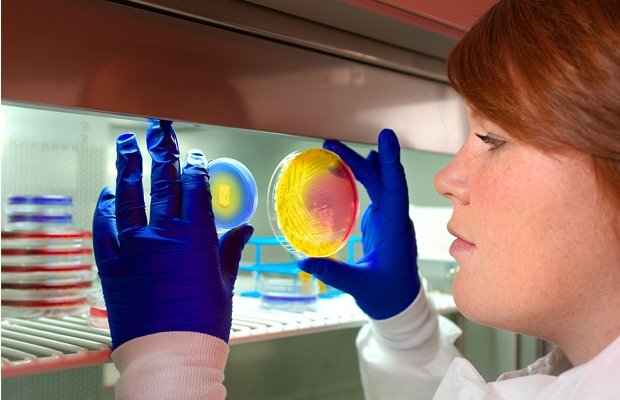

Pfizer earnings beat expectations as it reiterates full year forecast
US drugs giant Pfizer has reported second quarter earnings just beating analysts’ estimates as it prepares to split its commercial operations (release).
Adjusted income fell ten per cent to $4bn (£2.6bn) or 56 cents per share from $4.45bn or 59 cents per share the year before. Analysts had expected to see earnings per share of 55 cents.
Net income increased by more than 400 per cent to $14.1bn from $3.25bn a year earlier, drivne by the spin off of its animal health business and a patent settlement.
However, revenues fell by more than expected – by seven per cent to $12.97bn versus expectations of $13.01bn. This was driven by an operational decline of four per cent, primarily due to the loss of exclusivity on Lipitor, and an unfavourable impact from foreign exchange of three per cent.
Pfizer is planning to separate its commercial operations into two units for branded products and a third for generics. The company hopes this can help breath fresh life into its core drugs business and boost the value of consumer and off-patent established brands.
Pfizer reiterated its full year earnings of $2.10 to $2.20 per share.